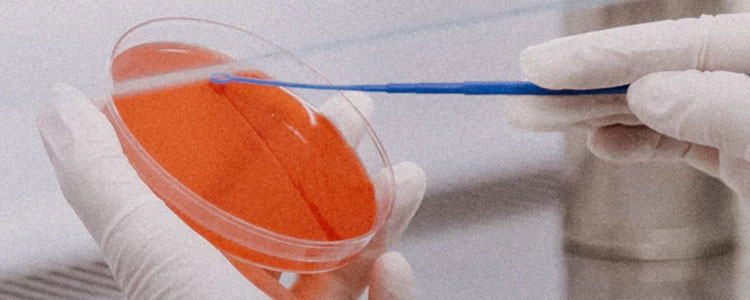

微納米粒檢測
NANOPARTICLE DETECTION
NANOPARTICLE
DETECTION
微納米粒檢測
了解微納米粒檢測技術在各個測試環境下的應用
主站蜘蛛池模板:
91最新地址|
欧美一区二区三区性视频|
国产精品videosex极品|
欧美在线中文|
中文字幕乱码一区av久久不卡|
超级碰碰色偷偷免费视频|
日韩午夜片|
国产99久久九九精品无码|
亚洲午夜无码毛片av久久|
奇米二区|
九九综合va免费看|
色与欲影视天天看综合网|
国内精品伊人久久久久777|
日本大学生三级三少妇|
欧美va天堂在线电影|
国产国产人免费人成免费|
国模欢欢炮交啪啪150|
国产人妻精品无码av在线|
亚洲玖玖玖|
国产三级无码内射在线看|
精品综合|
亚洲人成网站在线在线观看|
国产91在线看|
被灌满精子的少妇视频|
亚洲亚洲人成网站网址|
亚洲18色成人网站www|
日本阿v免费观看视频|
sese在线视频|
国产精成人品日日拍夜夜免费|
国产综合在线观看|
午夜亚洲福利在线老司机|
久久人人干|
韩国乱码片免费看|
超级黄色毛片|
强行糟蹋人妻hd中文字|
成年人午夜影院|
少妇粉嫩小泬喷水视频www|
无码一区二区|